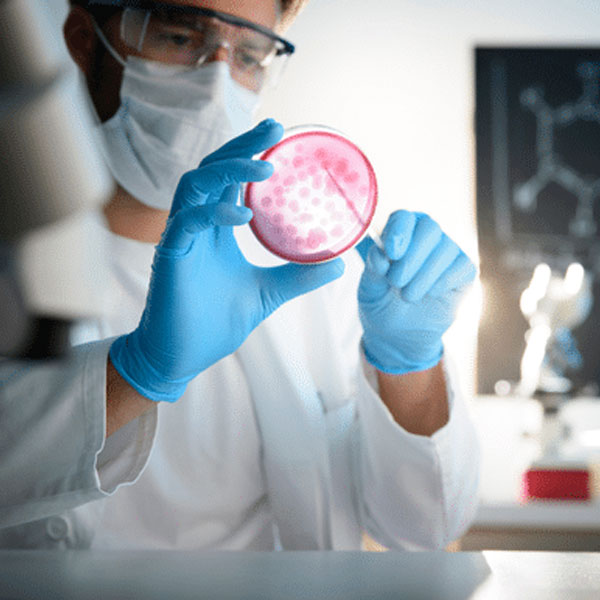

LABORATORIO MICROBIOLÓGICO
Desde 1981 Brindando Servicio en San Martín, Bs As.
LADIAC trabaja junto a profesionales asesores, brindándole una amplia gama de servicios analíticos que le permiten optimizar y acelerar el proceso de investigación, desarrollo y comercialización de sus productos, ya sean innovadores y/o genéricos.
Desde un simple estudio a un proyecto de desarrollo completo, nuestra experiencia, capacidad y flexibilidad permiten ofrecer a nuestros clientes soluciones a medida de sus distintas necesidades.
Somos una empresa con certificación ISO 9001:2015.
Nuestro concepto facilitador

ANÁLISIS DE AGUA
Art 982 del Código Alimentario Argentino. Atención a la industria, instituciones, consorcios y privados.
CHALLENGE TEST
Challenge Test-Test de Eficacia Antimicrobiana del sistema conservante para la industria cosmética.

COSMÉTICA
Control Higiénico I y II según ANMAT. Hongos y Levaduras. Hisopados de Manos y Superficies.
CONTACTARSE CON LABORATORIO DE MICROBIOLOGÍA
Whatsapp:
+54 9 11 5868-9462
Email:
asesora@ladiac.com.ar
